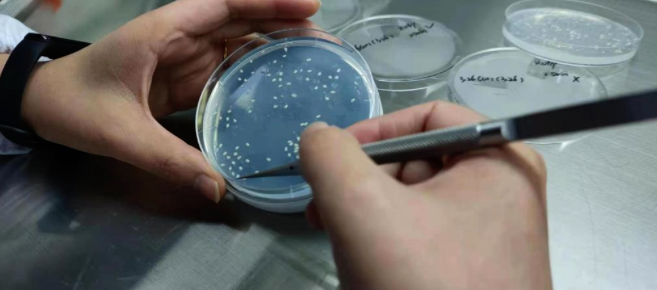
截屏2022-10-27 19.00.00.png

艾迪晶生物获数千万元天使投资,解决生物育种卡脖难题 | 济峰生态
2022-10-27
编者荐语:
济峰资本领投生物育种公司艾迪晶生物,是济峰资本在基因编辑生物育种领域的重要布局。

近日,生物育种公司艾迪晶生物宣布获得数千万元天使轮融资,本轮融资由济峰资本领投,涌铧投资跟投。根据创始团队透露,此轮融资将主要用于核心研发的继续投入、产品管线的深度布局以及现有成熟品种的商业化推广。
对艾迪晶生物的投资,是济峰资本在基因编辑生物育种领域的重要布局。
艾迪晶生物成立于2019年,是一家由具有丰富的商业化生物育种服务经验的团队创立,并由刘耀光院士领衔、多位兼备生物育种技术能力的高层次人才组建的一家国家高新技术企业,先后获得科技小巨人、3551创业人才、优质高端创业项目等荣誉,公司核心业务板块包括基因功能研究一站式服务、生物育种CRO服务、品种开发和经营等。
基因编辑育种相较于传统育种来说拥有精准高效、周期短、成本低的特点,国外已涌现出Inari、Benson Hill (BHIL)、Pairwise等上市及头部基因编辑育种公司。随着今年我国《农业用基因编辑植物安全评价指南(试行)》的出台以及第三次修正后的《中华人民共和国种子法》实施,一级市场持续涌现出超强技术团队领衔的生物育种公司,很多业内人士因此也将2022年视为中国生物育种的元年。从全球范围来看,2020年生物育种约占种子市场的50%左右,市场规模达到224亿美元,前景巨大。
在创立艾迪晶生物之前,创始人凌永国已经在生物育种行业有近10年的从业经验,打磨出一支实力强劲的基因编辑育种服务团队,核心团队拥有丰富的分子育种研发经验和高效的作物遗传转化技术。加上与具有国际领先植物多基因编辑和多基因叠加技术的刘耀光院士团队合作,形成了1+1远大于2的效果。
“随着我国基因编辑技术的迅速发展及我们团队在基因编辑技术上不断积累的成果,加上我们预判国家在基因编辑育种的政策会逐渐放开,这就是2019年艾迪晶生物成立的契机。”凌永国介绍。
不过创立之初,因为疫情地处武汉的艾迪晶遭遇了“长达76天封闭管理”、“团队被封实验室”、“项目进度被锁死”等一系列危机,然而由于核心团队的坚守,艾迪晶在疫情这几年发展迅速,团队人数从2019年7人增长到2022年的60人。也因为在基因编辑上的绝对技术优势和多年沉淀,艾迪晶赢得了越来越多客户信任,并迅速成长为国内生物育种第一梯队的技术服务商和研发商。
作物基因编辑育种有三大核心关键技术点,分别是编辑工具及技术、遗传转化技术以及重要性状基因位点发掘,艾迪晶在这三个方面均有较深的前瞻性布局。多基因编辑技术、多基因叠加技术和高通量植物遗传转化技术是公司的优势,并在后续的发展中通过自主或联合开发了具有专利保护的抗除草剂、抗虫等基因位点。

凌永国举例,他们曾给一家种子公司同时解决水稻的粒型、口感、香味及矮杆问题,当时同时操作了8个基因,只用了3个多月,就一次性筛选出多株含有8个基因同时发生纯合突变的材料。如果用常规的杂交聚合去做,整个过程需要耗时2-3年左右。艾迪晶基因编辑技术可以做到30多个位点的同时编辑,多位点突变纯合效率可以达到20%;植物遗传转化技术中,目前艾迪晶已经成功转化20多个物种,覆盖玉米、大豆、水稻、油菜、番茄、拟南芥、草类、林木类、果蔬类等品种,且能在主要农作物,比如水稻、大豆、玉米、番茄等品类中不受品种的限制地进行遗传转化。

公司的先导编辑系统(prime editing,PE)打靶效率高达40%,处于全球先进水平。运用多基因编辑技术及先导编辑PE系统,艾迪晶还自主或合作开发了抗除草剂的水稻/陆稻、不同直链淀粉含量的稻米、矮杆的玉米、耐裂荚的大豆等优异种质材料。其中,基因编辑的耐除草剂陆稻新品种,将是国内首个自主研发的、耐HPPD类抑制剂除草剂的陆稻品种,填补该项研究的空白。
此外,公司非常重视知识产权的积累和布局,已获得知识产权30余项,包括发明专利、实用新型专利、软件著作权、植物新品种权、植物新品种审定等方面。
凌永国介绍,今年以来,艾迪晶业务进展飞快,实际营收超出预期35%。随着国家基因编辑育种政策的积极推进,以及投资方济峰资本和涌铧投资的加入,公司在品种管线上会持续加大研发的投入和力度,创制出更多符合市场需求的优良新品种。同时,公司聘任了原湖北省种子集团董事长袁国保先生作为公司种业顾问,深度布局国际、国内种业市场。
“粮食安全是国之根本,种子是农业的“芯片”,随着基因编辑育种政策的放开,中国种业将插上科技的翅膀,实现在国际上的弯道超车。“艾迪晶定能抓住历史机遇,为中国种业打好翻身仗贡献一份力量”,凌永国说。
艾迪晶创始人凌永国表示:济峰资本和涌铧投资的加入,将更快地推动艾迪晶在人才、技术、资本和管理四个维度的继续深度布局、整合、升级,开发出更多解决市场痛点的新品种,为“中国碗,盛中国粮”做出艾迪晶贡献。
济峰资本管理合伙人胡旭宇表示:基因编辑技术在生物育种领域的应用是颠覆式的革新,艾迪晶是济峰在生物育种领域的重要布局。公司拥有全球领先的基因编辑技术,刘耀光院士是农业基因编辑领域顶级的专家,尤其是在主粮方向引领潮流。我们相信艾迪晶在创始团队的带领下,可以尽快开发出具有商业价值的自主知识产权新品种,为中国种业带来全新发展动力。
济峰资本创立于2015年,是一家卓越的专注于医疗健康领域的风险投资机构,通过全方位的增值服务和全球化的视野为企业赋能,驱动创新,旨在为医疗行业的发展和人类健康带来长期价值。我们永葆创业初心,始终秉持“专业、谦逊、勤勉”的精神,长期持续地以战略伙伴关系帮助和服务创业者,帮助企业立足中国,放眼全球,成为伟大的企业。